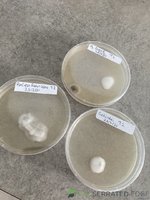

- User ID
- 6
Good tip with freezing the blue juice, I've read it can lose potency quite quicklyView attachment 3949
Made this up a few months ago.
Cold extraction with ice cubes melting over fresh cut shrooms in fridge for like 4-5days. Then drink or freeze for later.